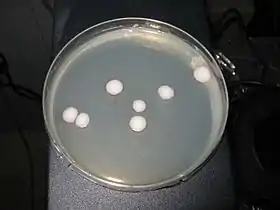

Kluyveromyces
Kluyveromyces é um género de levedura da família Saccharomycetaceae. Algumas das espécies, como K. marxianus, são teleomorfos de espécies de Candida.
| Kluyveromyces | |||||||||||||||
|---|---|---|---|---|---|---|---|---|---|---|---|---|---|---|---|
![]() | |||||||||||||||
| Classificação científica | |||||||||||||||
| |||||||||||||||
| Espécies | |||||||||||||||
| |||||||||||||||
O nome do gênero Kluyveromyces é em homenagem a Albert Jan Kluyver (1888-1956), que foi um microbiologista e bioquímico holandês.[2]
O gênero foi circunscrito por Johannes P. Van der Walt em Antonie van Leeuwenhoek vol.22 nas páginas 268-271 em 1956.
Referências
- Van der Walt, Antonie van Leeuwenhoek Ned. Tijdschr. Hyg. 22: 271 (1956)
- Burkhardt, Lotte (2022). Eine Enzyklopädie zu eponymischen Pflanzennamen [Encyclopedia of eponymic plant names] (pdf) (em German). Berlin: Botanic Garden and Botanical Museum, Freie Universität Berlin. ISBN 978-3-946292-41-8. doi:10.3372/epolist2022. Consultado em 27 de janeiro de 2022
This article is issued from Wikipedia. The text is licensed under Creative Commons - Attribution - Sharealike. Additional terms may apply for the media files.